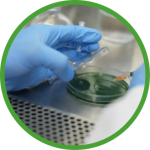
microbiologia-2x

LABORATORIOS




PLANTA LAQUINSA
En nuestra Planta Laquinsa contamos con un laboratorio de análisis químico de primera calidad para la agricultura con la más moderna tecnología.
Contamos con un equipo de profesionales multidisciplinario calificado para ofrecerle un servicio confiable y ágil. Además, hemos invertido en una sólida infraestructura que nos permite ofrecer servicios a diversas empresas de la industria agroquímica. Por ello garantizamos nuestros resultados gracias a la Norma NTE INEN ISO/IEC 17025:2018; por parte del Servicio de Acreditación Ecuatoriana (SAE).
Capacidad y servicios que brindamos:
- Analisis fisico-quimicos
- Estudio de almacenamiento acelerado
- Mejoramiento y desarrollo de productos
- Analisis de concentracion de alcohol (metodo de Gay Lussac)
- Analisis de ingredientes activos
PLANTA LAQUINSA
Km. 5.5 Via Duran – Tambo
Ecuador
Telf.: 042 590 695 – Ext. 107
09923705234 – 2560400
RECLAMOS O SUGERENCIAS
Comuniquese con nosotros a:
gdsalto@agripac.com.ec y
aperdomo@agripac.com.ec
CIDAC
El centro de Investigación Acuícola con sus siglas CIDAC propicia un estrecho vínculo con el sector productivo a través de servicios de experimentación, enfocados principalmente en camarón, además extiende sus servicios de laboratorio con analíticas para el control y toma de decisiones al sector camaronero.





SERVICIOS DE ANÁLISIS
CIDAC a través de sus análisis brinda a sus clientes resultados altamente confiables y a tiempo. Nuestros profesionales están siempre dispuestos atender sus requerimientos e inquietudes.
ANÁLISIS BIOLÓGICOS
ANÁLISIS FISICO-QUÍMICOS
MICROBIOLOGÍA
MOLECULAR
SUELO
AGUA
Microbiología
- Bacterias Totales
- Vibrio Totales
- Aeromonas y Pseudomonas
- Antibiograma
- Concentración Mínima Inhibitoria (MIC)
- Identificación bioquímica API 20 NE
- Identificación Bioquímica API 20 E

Detección de patógenos por q-PCR
- WSSV
- IHHNV
- EMS

Suelo
- Carbono Orgánico (%)
- Materia Orgánica (%)
- Nitrógeno Total (%)
- pH

Agua
- Alcalinidad (CO₃Ca)
- Amonio (NH⁴⁺)
- Calcio (Ca⁺²)
- Carbonato de
- Magnesio
- Conductividad
- Dureza total (CO₃Ca)
- Dureza iónica
- Dureza de Magnesio
- Dureza Cálcica
- Fósforo iónico (P⁺)
- Fosfatos (PO4¯)
- Magnesio (Mg⁺²)
- Nitratos (NO³¯)
- Nitritos (NO²¯)
- Potasio (K⁺)
- Total de nitrógeno amoniacal (TAN)
- Entre otros.
CIDAC
Km. 4.5 Via Duran – Tambo
Planta Balanfarina. Ecuador
Telf.: 042 593 490 – Ext. 3250

VER ALCANCE ESPECÍFICO DE ACREDITACIÓN EN